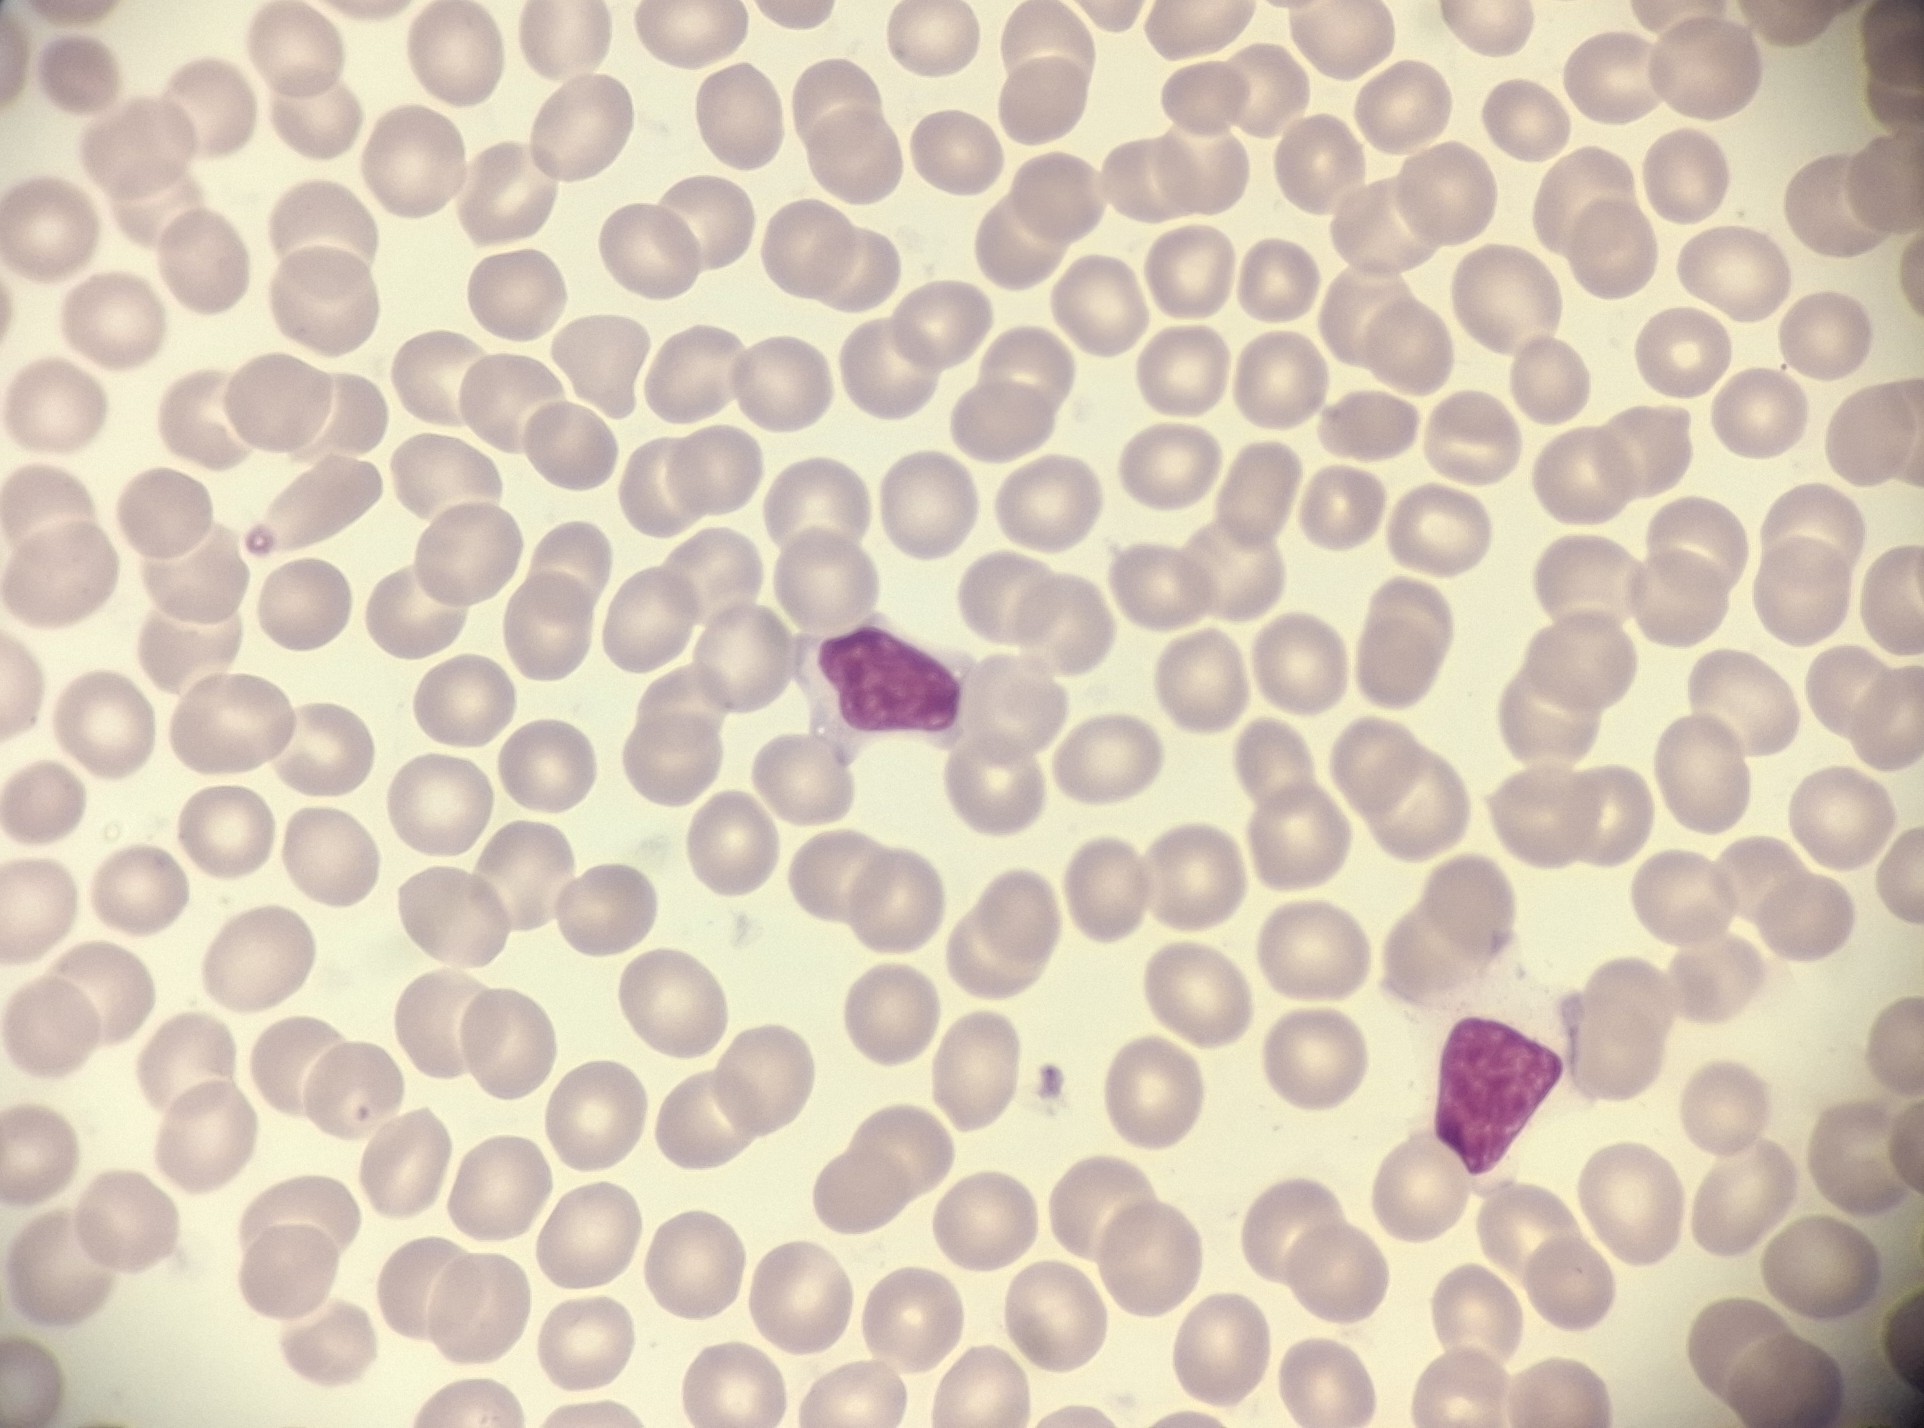

Brevet de Technicien Supérieur de Biologie Médicale
BTS BM
Quel métier ?

- laboratoires de biologie médicale de ville ;
- laboratoires de biologie médicale dans les hôpitaux ;
- l'Etablissement Français du sang ;
- laboratoire d'anatomocytopathologie ;
- laboratoires de biologie de la reproduction ;
- laboratoires de biologie vétérinaire éventuellement ;
- laboratoires de bioindustries éventuellement ;
- laboratoires de recherche éventuellement.
Le technicien supérieur de laboratoire de biologie médicale réalise les analyses sur les différents prélèvements (sang, urine, selles, crachat, sperme, biopsie, frottis...) faits dans un contexte médical. Il participe à l'évaluation de l’état de santé d’un patient et à sa prise en charge thérapeutique. Il peut également assurer les prélèvement sanguins ou nasopharyngés des patients et parfois assurer certains gestes de l'assistance médicale à la procréation.
Quelle formation ?
BLOC 1 : GESTION DU LABORATOIRE ET DEMARCHE QUALITE |
|
BLOC 2 : ANALYSES MEDICALES LES PLUS COURANTES |
|
BLOC 3 : AMELIORATION DES METHODES - PRATIQUES A VISEE THERAPEUTIQUE |
|
BLOC 4 : COLLABORATION AVEC DES PROFESSIONNELS |
|
BLOC 5 : PRELEVEMENTS BIOLOGIQUES |
|
Au cours des deux années de BTS, le futur technicien supérieur de biologie médicale sera formé pour être apte à réaliser des analyses de :
- biologie moléculaire comme la détection ou la quantification d’ADN ou d’ARN afin de diagnostiquer une infection virale par exemple ;
- microbiologie afin d'identifier les bactéries ou champignons ou parasites responsables d'une infection et les traitements possibles ;
- biochimie comme des dosages afin d'établir les afin d'établir les concentration de diverses substances dans les liquides biologiques (sang, urine, LCR, etc.) pour aider au diagnostic et au suivi des maladies métaboliques ou infectieuses ;
- hématologie pour analyser le sang afin de diagnostiquer et de suivre des anémies, des leucémies ou des troubles de la coagulation ... ou de garantir la sécurité d'une transfusion ;
- immunologie pour diagnostiquer des pathologies auto-immunes, évaluer une réponse vaccinale ou dépister des maladies infectieuses ;
- biologie de la reproduction afin de réaliser l’étude des gamètes pour l’aide au diagnostic de l’infertilité ou pour assurer le suivi technique des procédures d'Assistance Médicale à la Procréation (AMP).
En plus des enseignements professionnels, la formation comporte des enseignements généraux :
- des mathématiques et des sciences physiques et chimiques qui fournissent un support aux enseignements professionnels de la biologie ;
- de l'anglais qui est la langue scientifique internationale ;
- de la culture générale et expression, qui permet d'apprendre à communiquer avec efficacité et à adopter une posture critique, propice à la nuance et à la réflexion ;
- des plages horaires réservées au travail en autonomie en démarche de projet et pour de l'accompagnement personnalisé pour répondre à des besoins identifiés.
Deux tiers du temps du temps de formation se déroulent en effectif réduit.
Deux périodes de stages en entreprise (14 semaines réparties sur les deux années) complètent la formation dont la répartition horaire des différents enseignements est comme suit :
TS1 (Cours / TD-AT)
TS2 (Cours / TD-AT)
| |
Culture générale et expression | 2 / 0
2 / 0
|
Anglais | 1 / 1
1 / 1
|
Mathématiques | 1 / 1
1 / 1
|
Sciences physiques et chimiques | 2 / 1
2 / 1
|
Bloc 1 : gestion du laboratoire et démarche qualité | 1 / 2
1 / 2
|
Bloc 2 : analyses médicales | 2 / 8
2 / 7
|
Bloc 3 : améliorations de méthodes - pratqiues à visée thérapeutiques | 1 / 2
0 / 4
|
Bloc 4 : collaboration avec les professionnels | 2 / 2,5
1,5 / 4,5
|
Bloc 5 : prélèvements | 0 / 1
0 / 1
|
Quels débouchés ?

Dans la majorité des régions comme en Île-de-France, il existe une pénurie de main d'oeuvre dans le secteur et l'embauche est rapide et garantie.
Quel profil ?

Ils en parlent...
Juste après mon BTS, j'ai été embauchée dans un grand hôpital de région parisienne, secteur hématologie. Ce que j'adore dans mon boulot c'est la nouveauté constante notamment à la banque du sang, j'adore qu'un médecin avec 15 ans de métier me demande des explications sur des résultats... :-)
J'ai tellement de chose que j'adore dans mon boulot que c'est dur à résumer en fait !(Nawel)
J’ai travaillé dans différents laboratoires : un laboratoire de PMA, un laboratoire privé, un grand CHU parisien de premier plan, et maintenant dans un petit hôpital du sud de la France. J’aime beaucoup le contact que j’ai avec les services pour discuter de la clinique des patients et rendre des résultats qui seront utiles à la prise en charge. On est souvent remercié par les autres équipes car on reste un maillon indispensable.(Muhammed)
Après le BTS, j’ai débuté à l’hôpital en hematologie chez l'adulte puis j'ai évolué vers la pédiatrie en cytologie et hémostase. Franchement, j'aime vraiment bien mon métier, on se sent utile tous les jours !(Rooben)
J’ai décroché un poste en bactériologie dans un grand hôpital parisien quelques jours après avoir eu mon BTS, exactement ce que je voulais !! Et après 13 ans je ne me lasse pas de cette discipline passionnante et qui progresse jour après jour. Ce qui me plait c’est de continuer à apprendre de nouvelles choses, participer au bon fonctionnement et à l’évolution de mon labo en étant référente sur plusieurs postes.(Joëlle)
Découvrez une présentation vidéo du BTS Analyse de Biologie Médicale avec notre partenaire Thotis Media. Depuis le tournage de cette vidéo, le BTS a été réformé, les noms des matières et les volumes horaires sont donc différents, mais beaucoup d'éléments restent communs.
Nous utilisons des cookies et des technologies similaires pour améliorer votre expérience sur notre site Web.